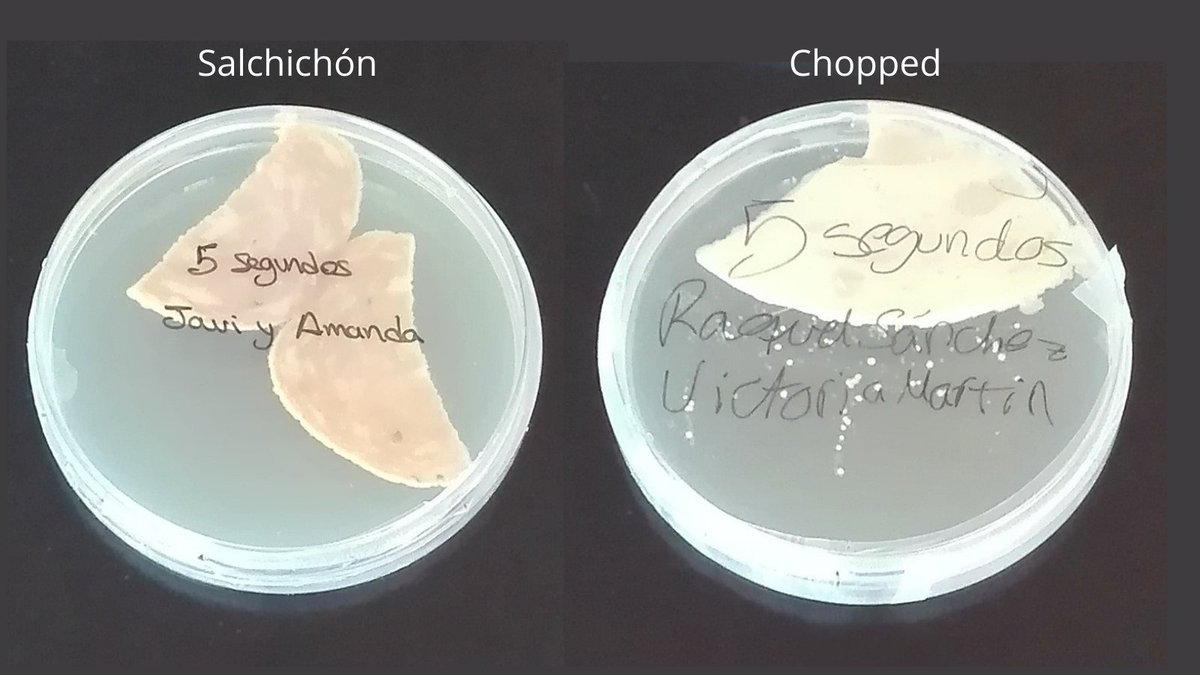

Se cae cualquier alimento al suelo y hay algo en nuestro interior que hace que nos agachemos rápidamente a por ello 🥴 A ver si van a pasar cinco segundos y se va a llenar de bacterias ¿no? 🦠🦠 ¿Qué hay de verdad (o mentira) en la REGLA DE LOS5⃣SEGUNDOS? Abro un mini-hilo 🧵⬇️ 

➡️ Obviamente, por muy listos que a mí me parezcan los microorganismos, aún no hemos descubierto que sepan contar hasta 5 😜 Aunque sí que hay algo de verdad en que el tiempo que pasa el alimento en el suelo hace que pueda estar más o menos colonizado ⏳⏳
En estas placas vemos cachitos de plátano que han sido mantenidos distintos tiempos en el suelo antes de ser colocados en los medios de cultivo para favorecer el crecimiento de bacterias 🧫🧫 Vemos como a los 5 segundos hay algo de contaminación pero a los 30 ya es una locura 😱 

➡️ Otro parámetro muy importante es qué características tiene el alimento. Cuanto más húmedo y pegajoso sea más probabilidad de que las bacterias del suelo se peguen a él muy rápidamente.
Tras5⃣segundos en el suelo, la cantidad de bacterias que han colonizado el chopped (más pegajoso y mojadito) es mucho mayor que las que han podido “subirse “ al salchichón, que es más seco 🧫🧫🧫
➡️ Y por último hay que tener en cuenta en qué tipo de superficie se ha caído. Aunque parezca increíble se ha demostrado que la alfombra es lo que menos favorece la transferencia de las bacterias a los alimentos y sí se produce muy eficazmente en azulejos, madera o acero 😱
Varios artículos científicos han estudiado la transferencia de bacterias patógenas en distintas superficies y mirad como la alfombra es la que mejor funciona para contener que las bacterias pasen al alimento cuando se cae 👀👇 

Estas fotos forman parte de una actividad de la Semana de la Ciencia que hicimos hace unos años en @BiologiaUcm donde lo pasamos pipa desmontando la regla de los 5 segundos 🤭🦠🤭 



🔴 Y ahora que ya tienes toda la información queda a tu elección si tras cinco segundos en el suelo te lo comes o no… Eso sí, recuerda que los microorganismos no han ido al cole y a lo mejor no saben contar 🤪 

• • •
Missing some Tweet in this thread? You can try to
force a refresh









